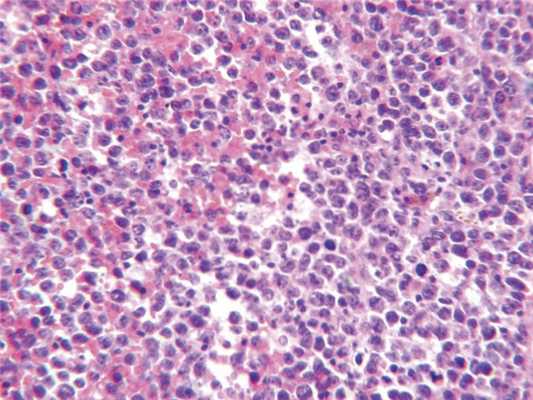

Лимфома сердца на рентгенограмме, КТ
Добавил пользователь Алексей Ф. Обновлено: 01.11.2025
ФГБУ «Федеральный центр сердечно-сосудистой хирургии» Минздрава России, Астрахань
ФГБУ "Федеральный центр сердечно-сосудистой хирургии" Министерства здравоохранения России, Астрахань
ФГБУ «Федеральный центр сердечно-сосудистой хирургии» Минздрава России, Астрахань, Россия
ГБУЗ АО Астраханской области «Патологоанатомическое бюро», Астрахань, Россия
ГБОУ ВПО «Астраханский государственный медицинский университет» Минздрава России, Астрахань, Россия ,
Хирургическое лечение первичной лимфомы сердца
Первичные и вторичные опухоли сердца представляют собой крайне интересный, но мало изученный исследовательский материал. Известно, что вторичные опухоли сердца встречаются чаще первичных. Так, в одном из наблюдений, включавшим 12 485 аутопсий, выявлено 154 случая метастатического поражения сердца и всего 7 случаев первичных опухолей, источником метастазов стали карциномы легких и пищевода [8].
Первичные опухоли сердца (ПОС) подразделяют на доброкачественные и злокачественные. Среди доброкачественных, частота встречаемости которых составляет до 75% среди ПОС, в половине случаев выявляют миксому, а среди случаев злокачественного поражения сердца — ангиосаркому [10]. Самой редко встречающейся ПОС является лимфома, случаи которой в отечественной литературе описаны в единичных публикациях [1, 2].
Первичная лимфома сердца (ПЛС) поражает прежде всего правые камеры сердца, изолированно поражает миокард и перикард, не имея экстракардиального распространения. Принято выделять В-клеточные (составляют большинство ПЛС), Т-клеточные и NK-клеточные лимфомы [7].
С клинической точки зрения, необходимо определить, является опухоль индолентной (вялотекущей) или агрессивной. B-клеточная лимфома является агрессивной опухолью. Прогноз при данном заболевании крайне неблагоприятный, после установления диагноза — средняя 7-месячная выживаемость [9].
Клиническое наблюдение
Больной Ю., 70 лет, был доставлен в стационар реанимационной бригадой с клиникой выраженной дыхательной недостаточности (одышка в покое, ортопноэ, снижение сатурации кислорода в крови до 78%).
За 2 мес до госпитализации у больного внезапно появилась прогрессирующая одышка. При обследовании по месту жительства по данным эхокардиоскопии (ЭхоКС) выявлено образование правого предсердия (ПП). Вскоре развился синдром верхней полой вены (ВПВ).
При поступлении пациент госпитализирован в отделение интенсивной терапии, переведен на искусственную вентиляцию легких (ИВЛ) и обследован. Клинический и биохимический анализы крови не выявили каких-либо отклонений от нормы. Маркеры вирусных гепатитов и ВИЧ отрицательные.
По результатам ЭхоКС выявлено увеличение левого предсердия (ЛП) до 4×5 см и 8×4,4 см, увеличение правого предсердия (ПП) до 6×5 см, отмечена дилатация правого желудочка (ПЖ). Выявлено гиперэхогенное образование, занимающее ¾ ПП и ПЖ, не связанное с межпредсердной перегородкой, создающее значительное препятствие притоку крови. Трикуспидальный клапан не дифференцирован, вероятно, за счет сдавления (рис. 1).

Рис. 1. Трансторакальная ультразвуковая картина опухоли (Philips iE33). Видно образование, занимающее большую часть правого предсердия и часть правого желудочка.
По данным компьютерной томографии (КТ), в ПП обнаружено дополнительное образование дольчатого строения, с полицикличными ровными контурами, довольно однородной структуры, занимавшее всю полость ПП и пролабирующее в полость ПЖ на ½ его объема. Размеры образования 5,9×7,5×8 см. Выраженный венозный коллатеральный кровоток. Полые вены без дефектов наполнения (тромбов) в просвете (рис. 2).

Рис. 2. Рентгеновская компьютерная томография с контрастным усилением в 3D-реконструкции (Siemens SOMATOM Sensation 64). Стрелкой обозначена коллатеральная сеть венозного возврата в системе верхней и нижней полой вен, развившаяся в связи с обструкцией правого предсердия.
По результатам коронарографии поражения коронарного русла не выявлено.
Принято решение о выполнении экстренного оперативного вмешательства.
Интраоперационно в ПП обнаружено плотное, бугристое образование больших размеров, пролабирующее в ПЖ через правое атриовентрикулярное отверстие (рис. 3, 4).

Рис. 3. Фотография операционного поля. Стрелкой обозначен участок правого предсердия, прорастающий опухолью.

Рис. 4. Макропрепарат опухоли дольчатого строения, цвета вареной рыбы, окруженной тромбами.
Образование покрыто тромбами, фиксировано к стенке ВПВ на значительном протяжении. ВПВ прочно сращена с окружающими тканями, стенка ее инфильтрирована, с признаками прорастания вышеуказанного образования. С учетом подозрения на онкологический процесс образование удалено вместе с устьем ВПВ и частью ПП в области площадки данного образования. В связи с вовлечением в воспалительный процесс ВПВ и окружающих тканей дальнейшая мобилизация ВПВ не производилась. В ПЖ образований не обнаружено. Ушито открытое овальное окно, ушко ЛП ушито снаружи. Дефект П.П. и ВПВ восстановлен заплатой из ксеноперикарда размером 4×7 см. Таким образом, выполнено нерадикальное удаление объемного образования ПП, аннулопластика трикуспидального клапана по Де Вега.
Ближайший послеоперационный период протекал с явлениями энцефалопатии и периодами психомоторного возбуждения, почечной дисфункции без редукции диуреза.
Из отделения реанимации пациент переведен в кардиохирургическое отделение на 4-е сутки после операции. Послеоперационный период протекал с медленной активизацией, однако без каких-либо осложнений. Пациенту решено провести дообследование на предмет уточнения первичной локализации онкологического процесса и возможного его метастазирования (КТ, бронхоскопия, фиброгастродуоденоскопия (ФГДС), УЗИ органов малого таза), при этом данных о новообразованиях и метастазах не получено.
При гистологическом исследовании обнаружена опухоль, состоящая из округлых атипичных клеток с большим количеством митозов, разряжением стромы вокруг отдельных клеток (рис. 5).
Рис. 5. Гистологическое исследование. Окраска гематоксилином и эозином. Ув. 400.
Дифференциальная диагностика проводилась с лимфомой, тимомой, злокачественной нейроэндокринной опухолью.
При иммуногистохимическом исследовании установлено, что ткань опухоли представлена В-клеточной лимфомой. Признаки выраженной экспрессии общего лейкоцитарного антигена (ОЛА) опухолевыми клетками. Опухолевый инфильтрат с интенсивной мембранной экспрессией клетками опухоли антигена CD20 (рис. 6).

Рис. 6. Иммуногистохимическое исследование. Иммуноморфологическое выявление CD20. Ув. 400.
Заключение
Экстранодальная диффузная крупноклеточная В-клеточная лимфома сердца. Пациент был выписан в удовлетворительном состоянии без признаков сердечной, дыхательной недостаточности под наблюдение онколога.
В ближайшем отдаленном периоде (через 7 мес после выписки) пациент умер. Аутопсия не произведена.
Как уже было отмечено, ПЛС встречается крайне редко. Клинические симптомы данной опухоли значительно варьируют и зависят от ее локализации и размеров. Нарушение ритма и проводимости, перикардиальный выпот, одышка, недостаточность кровообращения служат наиболее частыми клиническими проявлениями заболевания [1, 4, 6, 11]. Реже к патологической картине присоединяется синдром ВПВ и эмболия ветвей легочной артерии [3, 5]. Какой-либо специфической симптоматики, характерной для ПЛС, не наблюдается, что подтверждает наш случай.
Для диагностики объемного образования могут быть использованы ЭхоКС, КТ и МРТ сердца. С целью окончательной верификации диагноза необходимо использовать гистологические и иммуногистохимические исследования с проведением дифференциальной диагностики опухоли.
Предпринятое хирургическое вмешательство значительно способствовало улучшению качества жизни больного.
В вышеописанном случае выполнить радикальное иссечение опухоли не представлялось возможным. Данная опухоль относится к агрессивному типу ПЛС. Данное стечение обстоятельств только лишь усугубляло прогноз выживаемости пациента. Вследствие того, что аутопсия не производилась, мы можем лишь предполагать, что пациент скончался от быстротечного роста опухоли и возможного метастазирования.
По данным литературы [9], средняя продолжительность жизни после установления диагноза ПЛС не превышает более полугода. В нашем клиническом случае мы получили аналогичный результат.
Поражение легких при лимфоме

Лимфома (лимфоролиферативный процесс) — это группа онкологических процессов с поражением лимфоцитов (клеток иммунной системы), которые сопровождаются изменениями в лимфатических узлах и сосудах. При этом может происходить метастазирование — миграция злокачественных клеток в соседние органы и ткани с образованием вторичных очагов рака. Увеличенные узлы при лимфоме (> 1 см в поперечнике) — плотные и абсолютно безболезненные, поэтому выявляемость заболевания на ранней стадии сравнительно низкая. В этой статье мы расскажем, какие бывают лимфомы, о симптомах, которые должны насторожить, о визуализации патологических изменений на КТ.
Лимфома легких — что это?
Лимфатическая система легких напоминает ветвистое дерево — ее сосуды пронизывают грудную клетку по всей длине и отвечают за лимфоток. Здесь расположено 13 разновидностей лимфотических узлов, классифицируемых по 5 группам:
1.Надключичные лимфатические узлы;
2.Верхние медиальные лимфатические узлы (паратрахеальные, преваскулярные, превертебральные);
3.Аортальные лимфатические узлы;
4.Нижние медиастинальные лимфатические узлы;
5.Корневые, долевые, (суб)сегментарные лимфатические узлы.
В узлах фильтруется лимфа и происходит созревание лимфоцитов. Лимфомы возникают в лимфатических узлах.
Поскольку лимфатическая система представляет собой обширную сеть сосудов, капилляров и полостей, то злокачественные клетки могут распространиться по всему телу, образовав множественные диссеминированные метастазы.

Диагностика лимфомы легких
Обычно медицинские специалисты отдают предпочтение МРТ, поскольку отсутствует лучевая нагрузка однако в случае с обследованием воздушной ткани легочной паренхимы, которая в норме практически не содержит жидкость, наиболее подробные результаты обследования и детализированное изображение можно получить с помощью КТ легких. Если лимфома выявлена на МРТ, и у врача есть подозрение, что раковые клетки мигрировали в костную ткань, то пациенту будет рекомендовано дополнительное обследование костей. В ходе компьютерной томографии исследуют ткани разной морфологии, попадающие в зону интереса: кости, внутренние органы, сосуды. Для диагностики последних необходимо дополнительное контрастирование.
Симптомы лимфомы лёгких
Основным симптомом, по которому проще всего заподозрить лимфому легких, является увеличение лимфоузлов, локализованных в области ключиц, шеи, средостения, между ребрами. Некоторые узлы спрятаны в самой грудной клетки и не пальпируются. В таком случае лимфома дает о себе знать только тогда, когда увеличивается в размере и начинает давить на соседние органы, что вызывает дискомфорт.
Важно понимать, что увеличение лимфоузлов не является специфическим признаком злокачественной лимфомы. Оно наблюдается после антибактериальной терапии и при любом инфекционно-воспалительном заболевании — педикулезе, ОРВИ, инфекциях ротоглотки и гортани (включая заболевания стоматологического характера), при болезни кошачьих царапин (лимфоузлы увеличиваются в ответ на повреждение кожи или укус, но не сразу, а в течение последующих 3-20 дней).
Обычно лимфоузлы, увеличенные из-за воспалений, при пальпации болят и вызывают дискомфорт. При лимфоме узлы безболезненные.
Некоторые вирусы способны менять нормальную структуру ДНК лимфоцитов таким образом, что клетки превращаются в злокачественные. Так вирус Эпштейна-Барр (ВЭБ) или ВИЧ-инфекции в анамнезе существенно повышает риск развитие лимфом.
К ранним симптомам лимфомы легких относится:
- Усталость, общая слабость;
- Высокая температура (около 38 градусов), лихорадка;
- Гипергидроз (преимущественно в ночное время).
В течение первых четырех недель проявляются и другие симптомы лимфомы лёгких:
- Увеличение лимфоузлов;
- Потеря аппетита и веса;
- Дисфагия (затрудненное глотание);
- Боль и дискомфорт в грудной клетке.
У некоторых пациентов наблюдается кожный зуд. Если лимфома сдавливает органы дыхания или происходит их поражение агрессивными раковыми клетками, возможны затрудненное дыхание, кашель, одышка.
Диагностировать лимфому самостоятельно невозможно, необходимо медицинское исследование внутренних органов и тканей лимфатической системы методом КТ или МРТ.

Лимфома легких — это рак?
Не всегда. Однако к лимфомам относятся преимущественно злокачественные новообразования лимфатической системы, которые формируются из-за бесконтрольного накопления патологически измененных лимфоцитов. Исключением могут быть индолентные лимфомы. Они не требуют лечения, однако наблюдать их тоже важно. Если при этом у пациента проявляется вышеописанная симптоматика (температура, лихорадка, боль в грудной клетке), то обследование и лечение таких лимфом должно проводиться обязательно.
Злокачественные клетки-лимфоциты обладают формой, отличной от «правильных» клеток, и представляют собой фатальный «сбой» в работе организма. У таких клеток возникают совсем другие функции - они производят огромное количество белков и токсинов, при этом не уничтожаются клетками иммунной системы как враждебные.
Лимфомы не всегда являются первичным очагом онкологии. Патологически увеличенный узел или их группа (диссеминированная или локализованная в одном месте) часто бывает следствием метастатических процессов. Это происходит в связи с тем, что лимфатический узел выполняет функцию фильтра и накапливает в себе злокачественные клетки, отделившиеся от первично пораженного органа. В таком случае важно не только выявить лимфому, но и первичный очаг. Увеличение лимфоузлов легких может указывать на рак легких, молочной железы, средостения, желудка, то есть органов, расположенных в непосредственной близости.
Уточнить диагноз относительно доброкачественного или злокачественного новообразования можно по результатам биопсии (гистологического исследования образца ткани). Также пациент сдает клинический и биохимический анализы крови.На КТ легких врачи выявляют новообразование, могут оценить его размер, распространенность увеличенных лимфоузлов, однако сделать точный вывод о разновидности опухоли без анализов не представляется возможным.
Какие бывают лимфомы?
Первично лимфомы принято делить на две большие группы:
- Лимфомы Ходжкина / лимфогранулематоз (болезнь Ходжкина, ходжинские лимфомы),
- Неходжскинские лимфомы (лимфосаркомы, НХЛ).
По данным НМИЦ онкологии им. Н.Н. Блохина, в России заболеваемость неходжкинскими лимфомами в 1,5-3 раза превышает заболеваемость лимфогранулематозом.
Разница между этими лимфомами становится ясна после морфологического исследования образца ткани (биопсии). При болезни Ходжкина в пораженных лимфоузлах обнаруживаются крупные мутировавшие клетки Березовского — Штернберга — Рида. Ходжкинские лимфомы отличаются более агрессивным течением с ярко выраженной симптоматикой, но они легко поддаются лечению.
Пораженные Ходжкинской болезнью лимфоузлы чаще всего расположены над ключицами, в области шеи, подмышечных впадин, средостения.
Неходжкинские лимфомы помимо B-лимфоцитов, поражают еще и T-лимфоциты. Заболевание обычно протекает без выраженной симптоматики и тяжело лечится. Но сначала необходимо правильно определить разновидность неходжкинской лимфомы — актуальная классификация состоит из 30 наименований, включая:
- хронический лимфолейкоз;
- Т-клеточный лейкоз;
- фолликулярная лимфома;
- диффузная В-крупноклеточная лимфома;
- грибовидный микоз Сезари и др.
4 стадии лимфомы легких
Стадии течения заболевания определяют по распространенности лимфом и объему пораженной ткани:
- 1 стадия: в патологический процесс вовлечен 1 лимфоузел или 1 группа лимфатических узлов;
- 2 стадия: в патологический процесс вовлечены 2 и более групп узлов, расположенных по одну сторону от диафрагмы;
- 3 стадия: поражены лимфоузлы с обеих сторон, в патологический процесс вовлечено несколько групп.
- 4 стадия: помимо тканей лимфатической системы болезнь поражает внутренние органы (легкие, сердце и др.)
При этом симптомы лимфомы могут быть выраженными уже на первой стадии, а могут не ощущаться пациентом практически до четвертой.
Лимфома легких на КТ
Признаки лимфомы легких особенно выражены на четвертой стадии заболевания, когда болезнь поражает дыхательный орган. На КТ при этом будут видны увеличенные лимфоузлы, формирующие цепочки, конгломераты. При этом у пациента может также наблюдаться отек легких. Однако высокая разрешающая способность КТ позволяет выявить лимфому на ранней, первой стадии.
На КТ лимфомы, как и любые уплотнения, визуализируются сравнительно более светлым цветом. В норме воздушная легочная паренхима практически однородного темного цвета. Иногда таких уплотнений несколько и они диссеминированны. Контуры лимфомы четкие и ровные. Вокруг патологических очагов обнаруживаются участки «матового стекла».
Лимфома сердца на рентгенограмме, КТ
Кардиология:
Лимфома сердца - клиника, диагностика, лечение
Первичные лимфомы сердца — это редкие новообразования, которые составляют от 1,3 до 2% всех первичных опухолей сердца. Лимфомы могут развиваться у пациентов как с нормальным, так и с ослабленным иммунитетом, но чаще встречаются у последних.
Средний возраст больных на момент постановки диагноза «первичная лимфома сердца» — 62-67 лет с вариацией в диапазоне от 13 до 90 лет. Заболевание немного чаще встречается среди мужчин.
Наиболее частые клинические проявления первичных лимфом сердца — боли в груди, ХСН, перикардиальный выпот, сердцебиение и аритмии. У некоторых больных могут отмечаться общие симптомы. Менее распространенными проявлениями первичных лимфом сердца являются тампонада сердца, легочная и системная эмболии, синдром ВПВ и внезапная смерть.
В анализах крови в 16-23% случаев отмечается повышение уровня лактатдегидрогеназы, в 20% — повышение СОЭ. Изменения на ЭКГ неспецифичны, нередко обнаруживаются признаки АВ-блокады и наджелудочковых аритмий.
Рентгенография грудной клетки обычно в диагностике не помогает, а ЭхоКГ, особенно ЧПЭхоКГ, дает хорошую визуализацию лимфом сердца. Для выявления границ опухоли предпочтительнее КТ и МРТ, причем МРТ обладает наиболее высокой чувствительностью в диагностике первичных лимфом сердца. Однако признаки первичных лимфом сердца, выявляемые с помощью КТ и МРТ, неспецифичны, и для подтверждения диагноза необходимо гистологическое исследование.
Цитологическое исследование перикардиального выпота подтверждает диагноз в 60% случаев. Чреспищеводная, трансвенозная под контролем ЭхоКГ и чрескожная внутрисердечная биопсии позволяют получить образцы тканей для уточнения диагноза, однако в некоторых случаях (при невозможности использования данных методов) биопсию можно выполнить путем медиастиноскопии или торакотомии.
В 69-72% случаев первичные лимфомы сердца поражают его правые отделы. Одиночные поражения наблюдаются в 66% случаев, множественные — в 34%. Перикардиальный выпот встречается в 49% случаев, а в некоторых случаях может быть единственным проявлением заболевания. Средний размер первичных лимфом сердца составляет 7 см и может варьировать от 3 до 12 см.
Гистологически 80% первичных лимфом сердца, обнаруживаемых у иммунокомиетентных лиц, состоят из больших клеток В-клеточных лимфом, в некоторых случаях также встречаются клетки мелкоклеточных лимфом, лимфом Burkitt и Т-клеточных лимфом. У больных с ослабленным иммунитетом наиболее часто встречаются мелкоклеточные лимфомы с пересеченными ядрами и иммунобластные лимфомы. В постановке диагноза и определении специфического подтипа лимфомы могут помочь потоковая цитометрия и иммуногистохимическое исследование.
Первичные лимфомы сердца по агрессивности идентичны лимфомам других локализаций. Все лимфомы чувствительны к химиотерапии. Раннее ее начало с применением антрациклина и лучевой терапии (или без нее) — основа лечения первичных лимфом сердца, которое позволяет в большинстве случаев обойтись без радикального хирургического вмешательства. В последние годы успешное применение ритуксимаба, моноклональных антител к CD20, в комбинации с обычной химиотерапией дало надежду на увеличение выживаемости больных.
Однако в целом прогноз при первичных лимфомах сердца остается неблагоприятным даже на фоне проводимого лечения, учитывая агрессивную природу заболевания: 60% больных умирают в течение 2 мес после установления диагноза.
Прогноз у пациентов с ПТЛБ сердца существенно лучше, но во всех случаях в качестве начального лечения рекомендуется уменьшение иммуносупрессивной терапии.

Начальная кардиальная пимфома у пациента с желудочковой аритмией.
Неоднородное утолщение боковой стенки левого желудочка (черные стрелки) из-за проникающего роста лимфомы.
Перикардиальный выпот (белые стрелки) и билатеральный плевральный выпот.
Лимфома средостения
Лимфома средостения - опухоль злокачественного типа, развивающаяся из медиастинальных лимфатических узлов. В большинстве случаев лимфома средостения проявляется симптомами сдавления органов грудной полости: кашлем, затруднением дыхания и глотания, болями в грудной клетке; часто отмечается кожный зуд, ночная потливость. Лимфома средостения обнаруживается с помощью рентгенографии и КТ, диагноз подтверждается после проведения медиастиноскопии, гистологического и иммуноморфологического исследования фрагмента опухоли. Стандартные схемы лечения лимфом предусматривают проведение лучевой и химиотерапии; в некоторых случаях возможно хирургическое удаление опухоли средостения.
МКБ-10



Общие сведения
Под термином «лимфома средостения» понимаются неходжскинские (ретикулосаркома, лимфосаркома) и ходжкинские (лимфогранулематоз) лимфомы, первично поражающие лимфоузлы средостения. Среди всех опухолей средостения лимфомы составляют немногочисленную группу, тем не менее, частота поражения средостения при лимфогранулематозе составляет до 90%, а при неходжкинских лимфомах - до 50%. Медиастинальные лимфомы преимущественно обнаруживаются у лиц молодого и среднего возраста (20-45 лет).
Чаще всего лимфомы локализуются в передне-верхнем этаже средостения. Длительное индолентное (при лимфогранулематозе) или быстрое агрессивное (при лимфосаркоме) течение затрудняют своевременное выявление злокачественных лимфом. Решение этой проблемы требует интеграции усилий специалистов в области онкологии и торакальной хирургии.

Причины лимфомы средостения
В большинстве случаев непосредственная причина развития лимфомы средостения у конкретного пациента остается невыясненной. Однако гематологии известны факторы, повышающие вероятность возникновения лимфоидных неоплазий в популяции в целом. В группу повышенного риска включены пациенты:
- переболевшие инфекционным мононуклеозом, вирусным гепатитом С
- страдающие аутоиммунной патологией (СКВ, ревматоидным артритом и др.)
- те, чьи ближайшие родственники страдали гемобластозами
- имеющие генетические патологии, характеризующиеся первичным иммунодефицитом - это синдромы Вискотта-Олдрича, Луи-Бар (с-м атаксии-телеангиэктазии), Дункана и др.
- проходящие химиотерапевтическое или лучевое лечение по поводу других онкозаболеваний
- лица, получающие иммуносупрессивную терапию после трансплантации органов.
Среди неблагоприятных экзогенных факторов первостепенное значение придается производственным вредностям, экологическому неблагополучию, избыточной инсоляции, повышенному потреблению животных белков. Влияние употребления алкоголя и табакокурения на развитие лимфом однозначно не подтверждено.
Лимфомы средостения могут иметь первичное (изначально развиваются в медиастинальном пространстве) или вторичное происхождение (являются метастатическими новообразованиями или проявлением генерализованной формы лимфогранулематоза).
Симптомы лимфомы средостения
Ходжкинские лимфомы
Лимфогранулематоз средостения на начальных этапах протекает с минимальной симптоматикой. Нередко увеличение медиастинальных узлов, выявленных с помощью рентгенографии грудной клетки, является единственным признаком заболевания. Начальные клинические проявления обычно включают недомогание, повышенную утомляемость, бессонницу, пониженный аппетит, похудание. Характерны периодические подъемы температуры тела, сухой кашель, потливость по ночам, кожный зуд.
В поздних стадиях ходжкинской лимфомы средостения развивается компрессионный синдром, вызванный сдавлением структур средостения. Клиническим выражением этого синдрома может служить одышка, тахикардия, нарушение глотания, осиплость голоса, одутловатость шеи и лица (синдром верхней полой вены). При осмотре часто определяется увеличение шейных и подмышечных лимфоузлов, выбухание грудной клетки, расширение подкожных вен на груди.
Неходжскинские лимфомы
Чаще бывают представлены ретикулосаркомой, нодулярной или диффузной лимфосаркомой средостения. Они отличаются стремительным инфильтративным ростом и ранним метастазированием в легкие, костный мозг, селезенку, печень, кожу. При лимфосаркоме средостения преобладают признаки компрессионного медиастинального синдрома - затруднение дыхания, удушливый кашель, дисфония, цианоз, сдавление ВПВ.
Примерно у 10% пациентов с лимфомой средостения возникает экссудативный плеврит или хилоторакс, вызванные затруднением венозного или лимфатического оттока либо опухолевой инвазией плевры. В далеко зашедших стадиях опухоль может прорастать перикард, аорту, диафрагму, грудную стенку.
Диагностика
Лимфомы медиастинальной локализации не всегда диагностируются при рентгенологическом обследовании. Компьютерная томография, более детально, чем обзорная рентгенография позволяет рассмотреть конгломерат опухоли, увеличение лимфоузлов средостения, вовлечение паратрахеальных, трахеобронхиальных, прикорневых лимфатических узлов. Диагностическая значимость магнитно-резонансной томографии в верификации лимфом средостения признается не всеми авторами.

КТ ОГК. Объемное образование в средостении (патологически измененный лимфоузел), подтвержденная лимфома.
В дополнение к названным исследованиям используется УЗИ средостения, позволяющее оценить состояние внутригрудных лимфоузлов, недоступных для рентгенологической визуализации. Еще более высокочувствительным методом служит лимфосцинтиграфия с цитратом галлия. Для выявления компрессии трахеи и бронхов проводится бронхоскопия.
Поскольку тактика лечения лимфомы средостения определяется гистологическим и иммуногистохимическим типом опухоли, то обязательным этапом диагностики является биопсия. При увеличении доступных для пальпации лимфоузлов проводят эксцизионную, пункционную или прескаленную биопсию. В остальных случаях прибегают к операционной биопсии с помощью медиастиноскопии, парастернальной медиастинотомии, диагностической торакоскопии.
Дифференцировать лимфому средостения необходимо с другими медиастинальными опухолями, кистой средостения, саркоидозом, туберкулезом ВГЛУ, эхинококкозом, лимфаденитом различной этиологии, метастазами рака легкого, медиастинитом и др.

Лечение лимфомы средостения
Выбор протокола лечения лимфомы средостения зависит, главным образом, от типа и распространенности опухоли. При локальном лимфогранулематозе показана местная лучевая терапия. Иногда при изолированном поражении медиастинальных лимфоузлов прибегают к их хирургическому удалению с последующим лучевым лечением. Алгоритм лечения распространенных стадий лимфогранулематоза предусматривает проведение комбинированной химиолучевой терапии или полихимиотерапии.
Лимфосаркомы средостения также хорошо поддаются лечению с помощью консервативных методов - лучевой и химиотерапии. Многие онкологи и торакальные хирурги в последние годы высказываются за обоснованность хирургического удаления лимфомы средостения. В операбельных случаях операция может быть произведена уже на диагностическом этапе (так называемая тотальная биопсия), однако большинство хирургов признает целесообразность ее выполнения после предварительной противоопухолевой терапии (удаление остаточной опухоли).
Прогноз
Успешность лечения и выживаемость пациентов с лимфомой средостения во многом зависит от иммуноморфологического диагноза. 5-летний безрецидивный порог выживаемости при локальных формах лимфомы Ходжкина преодолевают 90% больных; при IV стадии лимфогранулематоза, даже после полихимиолучевого лечения этот показатель составляет не более 45%. Лимфосаркомы имеют гораздо более неблагоприятный прогноз ввиду быстрой генерализации процесса и частого рецидивирования.
1. Клинические рекомендации по диагностике и лечению лимфопролиферативных заболеваний/ Ассоциация онкологов России (авторский коллектив). - 2014.
2. Неходжкинские лимфомы из периферических T-клеток с преимущественным поражением средостения/ Мазурок Л.А. , Тумян Г. С., и др.// Клиническая онкогематология. - 2008 - Т.1, №3.
3. Дифференциальная диагностика В-клеточных лимфом средостения из крупных клеток: Диссертация/ Артемьева А.С. - 2015.
Лимфома
Лимфома - это злокачественное заболевание, которое характеризуется поражением лимфатических узлов и внутренних органов, в которых скапливаются «опухолевые» лимфоциты.
Акции

Полное обследование на онкологические заболевания для мужчин и женщин.

Онкоконсилиум может потребоваться как при лечении в «СМ-Клиника», так и пациентам других медицинских учреждений с целью получения альтернативного мнения.
«СМ-Клиника» предоставляет своим пациентам предоперационное обследование со скидкой до 72%!
Консультация врача-хирурга по поводу операции бесплатно!
Содержание статьи:
Лимфома (lymphoma) - злокачественная опухоль клеток иммунитета.При ней лимфоциты увеличиваются до гигантских размеров, бесконтрольно делятся и поражают лимфатическую систему: лимфоузлы, костный мозг, вилочковую железу.
От других онкологических заболеваний лимфома отличается диссеминацией по всему организму: с током лимфы переродившиеся злокачественные клетки попадают во внутренние органы и критически нарушают их работу. Болезнь долго течет бессимптомно, а когда начинает проявляться, то часто весь организм уже поражен.
Большинство лимфом характеризуется прогрессирующим течением и высокой злокачественностью с метастазированием. Тем не менее при раннем их выявлении благоприятный прогноз достигает ~90%.
Статистические данные о лимфомах:
- Ежегодно в России выявляют около 25 000 пациентов с раком данного типа - это 4% от всех онкобольных.
- Мужчины болеют чаще, чем женщины.
- Возрастной пик заболеваемости - 30-34 года и после 60 лет.
- В группе риска - больные с артритом двух и более суставов.
- Провоцирующий фактор - дефицит селена в организме.
- Есть предположение, что окрашивание волос чаще 1 раза в месяц темной краской увеличивают риск развития лимфомы на 26%.
- Считается что витамин Д обладает защитными свойствами против лимфомы.
- Благодаря современным методикам и препаратам за последние 10 лет смертность от лимфом в России снизилась на 27%.
Виды лимфом
Различают две основные группы заболевания - лимфому Ходжкина и неходжкинские лимфомы. Они развиваются из разного типа клеток, отличаются характером течения и по-разному реагируют на терапию.
Лимфома Ходжкина (ЛГМ) - лимфогранулематоз, злокачественная гранулема.ХарактеризуетсяпоражениемВ-лимфоцитов. Отличается агрессивным течением, при этом хорошо поддается лечению Источник:
И.И. Яковцова, В.Д. Садчиков, В.М. Садчикова, О.В. Долгая, С.В. Данилюк, А.Е. Олейник Лимфома Ходжкина: эволюция клинических классификаций // Вестник проблем биологии и медицины, 2013, №3, т.2 (103), с.62-69 .
Неходжкинские лимфомы (НХЛ) поражают не только В-, но и Т-лимфоциты. Всего выделено 30 подтипов.Большинство из них менее агрессивно, но и труднее лечится.
Классификация неходжкинских лимфом в соответствии с 4-й редакцией ВОЗ 2008 года:
- В-лимфобластная НХЛ;
- болезнь тяжелых цепей;
- В-клеточный пролимфоцитарный лейкоз;
- волосатоклеточный лейкоз;
- диффузная В-крупноклеточая НХЛ;
- лейкоз Беркитта;
- НХЛ из клеток мантийной зоны;
- лимфоплазмоцитарная НХЛ;
- медиастинальная диффузная В-крупноклеточая НХЛ;
- нодальная В-клеточная НХЛ маргинальной зоны;
- первичная экссудативная НХЛ;
- плазмоклеточная плазмоцитома/миелома;
- селезеночная НХЛ маргинальной зоны;
- фолликулярная НХЛ;
- хронический лимфолейкоз;
- экстранодальная В-клеточная НХЛ маргинальной зоны;
- Т-лимфобластная НХЛ;
- агрессивный NK-клеточный лейкоз;
- анапластическая крупноклеточная НХЛ с первичным поражением кожи;
- анапластическая крупноклеточная НХЛ с первичным системным поражением;
- ангиоиммунобластная Т-клеточная НХЛ;
- гепатолиенальная Т-клеточная НХЛ;
- грибовидный микоз Сезари;
- неуточненная периферическая Т-клеточная НХЛ;
- Т-клеточная панникулитоподобная НХЛ подкожной клетчатки;
- Т-клеточный лейкоз;
- Т-клеточный лейкоз из больших гранулярных лимфоцитов;
- Т-клеточный пролимфоцитарный лейкоз;
- экстранодальная NK/T-клеточная лимфома назального типа;
- энтеропатическая Т-клеточная НХЛ.
По характеру поражения и патогенезу все лимфомы делятся на 3 основные группы:
- агрессивные - для них характерно быстрое развитие с ярко выраженной симптоматикой;
- экстранодальные - первичное поражение формируется не в лимфатических узлах, а сразу во внутренних органах;
- индолентные - отличаются своим медленным и благоприятным течением; могут не требовать терапии, иногда достаточно регулярно наблюдаться у врача.
Для каждого вида лимфом существует особая схема лечения.
Стадии лимфом
В зависимости от распространенности опухоли определяют стадию патологического процесса. В соответствии с международной классификацией Ann Arbor выделяют 4 стадии заболевания:
- На 1-й стадии в лимфомный процесс может быть вовлечена одна группа лимфатических узлов.
- На 2-й допускается вовлечение двух и более групп по одну сторону от диафрагмы.
- На 3-й стадии опускается поражение лимфатических узлов по обе стороны диафрагмы.
- На 4-й стадии в процесс вовлекаются внутренние органы - мозг, сердце, печень, селезенка, желудок, кишечник.
Каждую стадию дополнительно маркируют титрами А и Б. Титр А указывает на отсутствие ключевых симптомов - лихорадки, сильной ночной потливости и резкого снижения веса. Титр Б указывает, что такие проявления есть.
Причины возникновения лимфом
Единого причинного фактора развития заболевания не выделено. На данный момент ученые считают, что патпроцесс запускается комплексом причин. К ним относят:
- наследственную предрасположенность;
- регулярные контакты с токсинами и канцерогенами;
- вирус герпеса, гепатита, хеликобактер пилори и другие инфекционные заболевания;
- аутоиммунные и иммунодефицитные состояния;
- повторяющиеся пневмонии;
- иммуноподавляющую терапию после пересадки почек, стволовых леток и т. д.;
- операции по вставке грудных имплантатов (предположительно).
Симптомы
Помимо основных симптомов - лихорадки, сильной ночной потливости и резкого снижения веса - для патологии характерны:
- слабость и повышенная утомляемость;
- повышение температуры;
- потеря веса;
- увеличение лимфатических узлов (часто, но не всегда; при этом они безболезненны и не уменьшаются в результате лечения антибиотиками, как при инфекционных заболеваниях).
Иногда возможен кожный зуд. При поражениях опухолью грудной клетки возможны затрудненное дыхание, одышка и кашель. При локализации новообразования в брюшной полости наблюдают расстройства пищеварения, тошноту, рвоту, распирающие боли в животе и нижней части спины. При поражении костного мозга больные жалуются на боли в костях. Если в патологию вовлечены лицевые и черепные структуры, есть жалобы на головные боли и распирающие боли в лице и шее.
Диагностика лимфом
Диагноз ставят по результатам микроскопического исследования биоптата - образца лимфоидной ткани. По результатам дифференциальной биопсии определяют тип опухоли.
Чтобы выявить опухоли в разных частях тела, применяют методы лучевой диагностики: рентгенографию, сцинтиграфию, магнито-резонансную, позитронно-эмиссионную и компьютерную томографию. При необходимости уточнить некоторые особенности патпроцесса назначают лабораторные анализы крови - иммуноферментотипирование методом проточной цитометрии, молекулярно-генетические и цитогенетические исследования Источник:
Wang HW, Balakrishna JP, Pittaluga S, Jaffe ES Diagnosis of Hodgkin lymphoma in the modern era // Br J Haematol. 2019 Jan;184(1):45-59. doi: 10.1111/bjh.15614. Epub 2018 Nov 8 .
Методы лечения
Наиболее распространенные методы лечения лимфом:
- лучевая терапия; ;
- радиотерапия;
- биологическая терапия;
- трансплантация стволовых клеток;
- хирургическое вмешательство.
Они применяются как в виде отдельных курсов, так и в комплексе. Выбор лечебной схемы зависит от вида опухоли и общего состояния больного.
Лечебная тактика
Индолентные лимфомы могут не требовать лечения, а только наблюдения онкогематолога. Терапия показана при первых признаках прогрессирования патпроцесса. При локализованных опухолях достаточно радиотерапевтического облучения пораженных структур. При генерализованных формах показана химиотерапия.
При агрессивном течении заболевания одна из наиболее эффективных лечебных схем - химиотерапия по протоколу СНОР в сочетании с иммунотерапевтическимипрепаратами из группы моноклональных антител. При высокоагрессивных видах опухолей может быть назначена высокодозная химиотерапия в сочетании с трансплантацией кроветорных стволовых клеток.
Лечение отдельных типов лимфом
Основной метод лечения лимфомы Ходжкина ЛГМ - химиотерапия. Противоопухолевые цитотоксины назначают в разных лекарственных формах. Химиотерапия носит цикличный характер - медикаментозные курсы чередуются с периодами реабилитации Источник:
Sermer D, Pasqualucci L, Wendel HG, Melnick A, Younes A Emerging epigenetic-modulating therapies in lymphoma // Nat Rev Clin Oncol. 2019 Aug;16(8):494-507.doi: 10.1038/s41571-019-0190-8 .
Радиотерапия - излучение высокой мощности - в качестве самостоятельного лечения ЛГМ может быть оправдана в отдельных случаях - когда в процесс вовлечена одна, максимум две группы лимфатических узлов. Чаще ее назначают в комплексе с химиотерапией. На поздних стадиях заболевания метод показан в качестве паллиативного лечения.
Биологические препараты - моноклональные антитела - при лечении лимфомы применяют для активизации иммунной системы. Лучевую терапию проводят регионарно, в области вовлеченных в онкологический процесс лимфоузлов.
В некоторых случаях при лечении ЛГМ оправдано удаление селезенки. Если увеличенные лимфатические узлы сдавливают соседние органы,может быть показано их иссечение.
При рецидивах заболевания, а также с целью уничтожения раковых клеток, на которые не действуют стандартные дозировки лучевой и химиотерапии, назначают высокие терапевтические дозы, разрушающие вместе с опухолью ткани костного мозга. После такого курса показана трансплантация органа. Взятые заранее собственные либо донорские стволовые клетки формируют новую иммунную систему.
Хорошие результаты в лечении НХЛ демонстрирует также комбинация лучевой и химиотерапии. В некоторых случаях успешно применяют инновационную техникулюмбально-пункционного введения противоопухолевых антител.
НХЛ с агрессивным течением плохо поддаются лечению. Наиболее эффективный метод борьбы с этим заболеванием - пересадка костного мозга.
Прогнозы
Прогноз для пациентов с лимфомами зависит от стадии процесса, возраста и состояния больного, а также от результатов терапии. При лимфоме Ходжкина пациенты молодого возраста на ранних стадиях,как правило, полностью выздоравливают. У 8 из 10 удается добиться устойчивой ремиссии. Пятилетняя выживаемость при 1-й стадии составляет 95%, при 4-й - 65%.
При НХЛ селезенки, лимфоузлов и слизистых средняя пятилетняя выживаемость - порядка 70%. При НХЛ ЖКТ, слюнных желез, глазных орбит средняя пятилетняя выживаемость - около 60%. Менее благоприятный прогноз у агрессивных НХЛ молочных желез, яичников, ЦНС и костей - пятилетняя выживаемость в среднем меньше 30%.
Клинические рекомендации после лечения лимфом и профилактика
Избегайте факторов риска - интоксикаций и контакта с канцерогенами. Вакцинируйтесь, а если заболели инфекционной болезнью - не занимайтесь самолечением.
При первых признаках лимфомы обращайтесь к врачу. Ежегодно проходите профилактические медосмотры, придерживайтесь правильного питания и старайтесь вести здоровый образ жизни.
Источники:
Михайлов Алексей Геннадьевич оперирующий онколог, врач высшей квалификационной категории, к.м.н. стаж: 21 год
Информация в статье предоставлена в справочных целях и не заменяет консультации квалифицированного специалиста. Не занимайтесь самолечением! При первых признаках заболевания необходимо обратиться к врачу.
Читайте также:
- Аутолиз почек и кишечника. Аутолитические изменения поджелудочной железы и селезенки
- Рентгенограмма, КТ, МРТ артропатии дугоотростчатых суставов шейного отдела позвоночника
- Респираторный бронхиолит, ассоциированный с интерстициальным заболеванием легких
- Помещение для лапароскопии. Персонал и оборудование для лапароскопии
- Введение лапароскопа. Осмотр органов брюшной полости при лапароскопии
